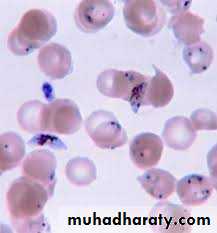
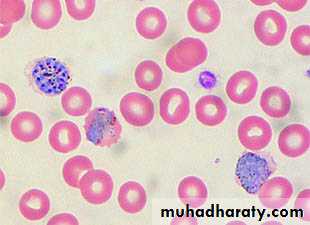

MALARIA
,AL- Abbasi A.M.,
MD, PhD, FRCP DCN, DTM&HProfessor of Infectious Diseases&
Clinical ImmunologyA mosquito-borne infectious disease of humans and other animals
caused by parasitic unicellular protozoon microorganism of the genus Plasmodium.Transmitted via a bite from
an infected female
Anopheles mosquito.
WHO
has estimated in 2010, 219 million documented cases of malaria.That year, the disease killed between 1.2 million people, many of whom were children in Africa.
Actual number of deaths is not known with certainty, as accurate data is unavailable in many rural areas, and many cases are undocumented.
Malaria is associated with poverty and economic development.
Malaria is prevalent in tropical and subtropical regions because rainfall, warm temperatures, and stagnant waters provide habitats ideal for mosquito larvae.Five species of Plasmodium can infect and be transmitted by humans.
The vast majority of deaths are caused by P. falciparum, its prevalence 75%,P. vivax prevalence 20%, most common outside Africa.
P. ovale, and P. malariae cause a milder form of malaria, rarely fatal.The zoonotic species P. knowlesi, prevalent in Southeast Asia, causes malaria in macaques but can also cause severe infections in humans.
Life cycle
Female Anopheles mosquito (the definitive host)motile infective form (sporozoite)
a human (the secondary host).
(hepatocytes), asexually (tissue schizogony),producing thousands of merozoites.
infect new red blood cells and initiate a series of asexual multiplication cycles (blood schizogony)
that produce 8 to 24 new infective merozoites, at which point the cells burst and the infective cycle begins a new.
Some merozoites immature gametocytes,
precursors of male and female gametes.mature in the mosquito gut.
The male and female gametocytes fuse and form a ookinete—a fertilized, motile zygote.Ookinetes develop into new sporozoites
migrate to the insect's salivary glands, ready to infect a new vertebrate host.sporozoites injected into the skin, in the saliva, when the mosquito takes a subsequent blood meal.
Only female mosquitoes feed on blood;
male mosquitoes feed on plant nectar, and do not transmit the disease.Females of the Anopheles genus of mosquito prefer to feed at night.
Malaria parasites can also be transmitted by blood transfusions, although this is rare.In the blood, the protests' travel to the liver to mature and reproduce
Genetic resistanceSeveral genetic factors provide some resistance to it including sickle cell trait, thalassemia traits, G6PD deficiency, and the absence of Duffy antigens on red blood cells.
Sickle cell trait causes a defect in the hemoglobin molecule in the blood. Instead of retaining the biconcave shape of a normal RBC, the cell to sickle or distort into a curved shape.
Infection causes red cells to sickle more, and so they are removed from circulation sooner.
This reduces the frequency with which malaria parasites complete their life cycle in the cell.
Signs and symptoms
Symptoms typically begin 8–25 daysfollowing infection, or later if anti malarial
medications are taken for prevention.
Initially flu-like symptoms,
but can resemble septicemia,
gastroenteritis, and viral diseases.
The presentation may include headache, fever, shivering, joint pain, vomiting, hemolytic anemia, jaundice, hemoglobin urea, retinal damage, and convulsions.
The classic paroxysm
a cyclical occurrenceof sudden coldness,
shivering and then fever
and sweating,
occurring every two days
(tertian fever) in P. vivaxand P. ovale infections,
and every three days
(quartan fever) for
P. malariae.
P. falciparum infection can cause recurrent fever every 36–48 hours or a less pronounced and almost continuous fever.
Severe malaria is usually caused by falciparum malaria which arise 9–30 days after infection.
Individuals with cerebral
malaria frequently exhibitneurological symptoms,
including abnormal posturing,
nystagmus, opisthotonus,
seizures, or coma.
Ring-forms and gametocytes of Plasmodium falciparum in human blood
Complications
Respiratory distress, up to 25% of adults and 40% of children with severe P. falciparum malaria.
Possible causes include respiratory compensation of metabolic acidosis,
Non cardiogenic pulmonary oedema,
Severe anemia.ARDS may develop in 5–25% in adults and up to 29% of pregnant women but rare in young children.
Co infection of HIV with malaria increases mortality.
Renal failure is a feature of black water fever.P. falciparum may result in cerebral malaria,
It is associated with retinal whitening, distinguishing malaria from other causes of fever.Splenomegaly, severe headache, hepatomegaly,
hypoglycemia,hemoglobinuria,
renal failure may occur.
Malaria in pregnant women with stillbirths, infant mortality and low birth weight,
Recurrent malaria
Symptoms of malaria can recur after varying symptom-free periods. Either recrudescence, relapse, or re infection.
Recrudescence:
Symptoms return after a symptom-free period, caused by parasites surviving in the blood as a result of inadequate or ineffective treatment.Relapse:
symptoms reappear after the parasites have been eliminated from blood but persist as dormant hypnozoites in liver cells.Relapse commonly occurs between 8–24 weeks and is commonly seen with P. vivax and P. ovale infections.
Re infection
Means the parasite that caused the past infection was eliminated from the body buta new parasite was introduced.
Re infection cannot readily be distinguished from recrudescence,although recurrence of infection within two weeks of treatment for the initial infection is typically attributed to treatment failure.
Diagnosis
Clinicalmicroscopic examination of
blood films
antigen-based rapid diagnostic tests (RDT)
PCR
Treatment
For P. falciparum artemisinins in combination with other antimalarials(artemisinin-combination therapy, or ACT),
to decreases resistance to any single drug component.
Additional anti malarials
amodiaquine, lumefantrine, mefloquin or sulfadoxine/pyrimethamine.
Another recommended combination
dihydroartemisinin and piperaquine.
ACT is about 90% effective when used to treat uncomplicated malaria.
To treat malaria during pregnancy,WHO recommends the use of
Quinine plus clindamycin early in the pregnancy (1st trimester),
and ACT in later stages (2nd and 3rd trimesters).
In the 2000s (decade), malaria with partial resistance to artemisins emerged in Southeast Asia.
Treatment of P. vivax requires both treatment of blood stages (with chloroquine or ACT) as well as clearance of liver forms with primaquine.
Severe malaria needs IV use of anti malarial drugs.
For severe malaria, artesunate is superior to quinine in both children and adults.Severe malaria needs supportive measures in ICU.
Monitorhigh fevers
seizures
poor breathing effort
low blood potassium.
Malaria prophylaxis
Chloroquine may be used where the parasite is still sensitive.In resistant malaria:
one of three medications
mefloquine (Lariam),
doxycycline or the combination of
atovaquone and proguanil hydrochloride (Malarone).
Doxycycline and the atovaquone and proguanil combination are the best tolerated.
Mefloquine is associated with death, suicide, and neurological and psychiatric symptoms.
The protective effect does not begin immediately, usually start taking the drugs one to two weeks before arriving and continue taking them for four weeks after leaving(with the exception of atovaquone/proguanil, which only needs to be started two days before and continued for seven days afterward).
The use of preventative drugs where malaria-bearing mosquitoes are present may encourage the development of partial resistance.
Preventative drugs is seldom practical for those who reside in areas where malaria exists, and their use is usually only in short-term visitors and travelers.
Due to the cost of the drugs, side effects, difficulty in obtaining anti-malarial drugs outside of wealthy nations.